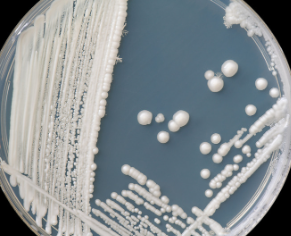

Infections
Chronic Infections | A Root Cause of PANS/PANDAS
Most people first hear about PANDAS in connection with strep. But chronic viral and bacterial infections could actually be a larger root cause of PANS and PANDAS than an active strep infection. Infections like Lyme, Bartonella and Mycoplasma, can become dormant infections by hiding in tissues or biofilms, evading the immune system’s detection. If these infections become chronic or remain hidden, they quietly fuel inflammation and can contribute to the development of autoimmunity and neuroimmune disorders like PANS and PANDAS. Understanding these chronic infections and how they interact with the immune system, is key to unraveling the root causes of PANS/PANDAS.
Microorganisms | Tiny Invaders with Big Impacts
Bacteria, viruses, fungi, and parasites are all types of microorganisms. These tiny organisms share a fundamental goal that’s common to all living things, the need to survive, reproduce, and feed. Like us, they require a steady supply of nutrients to do so.
And, these harmful microbes often turn to our bodies as their nutrient source. They break down our cells and tissues to get the nutrients they need. This causes the symptoms and damage caused by the infections. As microbes feed and multiply, they interfere with normal bodily systems and functions, which leads to an illness.
For an infection to take hold, the microbes need to enter the bloodstream. That usually means slipping past the body’s protective barriers, like the gut lining or nasal passages. Once inside, they can reach deeper tissues, including the brain and nervous system, where they’re harder to detect and harder to clear.
Breaching our Barriers
When a pathogen first enters the body, say after a tick bite or during a cold, it tries to cross barriers like the gut lining, mucous membranes, and skin. Early signs like a runny nose or sore throat mean the immune system caught the pathogen trying to sneak in. The stronger these front-line defenses are, especially the gut lining, the harder it is for pathogens to break through and enter the bloodstream.
But Lyme (Borrelia burgdorferi) and other stealth pathogens play a longer game. Once they get past those barriers and into the bloodstream, they face white blood cells designed to neutralize threats. That’s where things get tricky.
Lyme bacteria can change their outer surface proteins, essentially swapping disguises, so immune cells don’t recognize them. They can also form protective biofilms, which are slimy layers that shield them from immune attacks and sometimes antibiotics. Some forms of Borrelia spiral into tissue and shift into a dormant or cyst-like state, making them even harder to detect.
This ability to hide and adapt is part of what makes chronic Lyme and co-infections so difficult to treat. The microbes burrow into joints, nerve tissue, and even the brain, where immune surveillance is limited. That’s why many protocols target not just the bugs themselves, but also focus on breaking down biofilms, repairing tissue barriers (like the gut lining), and modulating immune function—so the body can recognize and clear the infection more effectively.
Common Latent Infections:
- Viral: Cytomegalovirus (CMV), Human Herpesvirus (HHV), Epstein-Barr Virus (EBV)
- Bacterial: Lyme disease (Borrelia), Bartonella, Mycoplasma, Streptococcus
- Fungal: Candida, Mold Colonization
- Parasites: Babesia, Toxoplasmosis
Chronic Infections and the Role of Inflammation
Chronic infections like Lyme and Epstein-Barr Virus (EBV), don’t always cause obvious symptoms, but they can keep the immune system on alert. This constant, low-grade immune activation can trigger systemic inflammation. However, the ongoing immune response can cause slow, ongoing systemic inflammation that quietly drains the body’s energy and resources. Over time, it wears down our resilience and makes it harder to handle new stressors or infections.
When the immune system stays stuck in defense mode, it can start to lose its ability to tell the difference between self and threat. That’s how autoimmunity begins. In PANS and PANDAS, this misfiring often targets the brain and nervous system.
These infections don’t just exist alongside autoimmunity, they feed it. The longer the cycle continues, the more entrenched it becomes. That’s why treating underlying infections and calming immune overactivation are both essential steps. It’s not just about chasing symptoms. It’s about restoring balance and giving the body the tools it needs to heal.

Viral Infections
Viruses like EBV (Epstein-Barr Virus), CMV, HHV-6, Coxsackie, and herpesviruses can linger in the body long after the initial illness has passed, continuing to stoke immune dysfunction. Many PANS kids flare with every cold or virus because their immune system struggles to regulate properly after viral exposure. Supporting immune resilience and calming inflammation is key here, especially during viral reactivations.
More details on chronic viral triggers coming soon.
Bacterial Infections
Bacterial infections like Strep, Mycoplasma, Lyme disease, and co-infections like Bartonella are well-established triggers in PANS/PANDAS. These pathogens don’t just cause acute illness; they can hijack the immune system and trigger autoimmune responses that inflame the brain and nervous system. Some infections can hide in tissues or shift into chronic, low-grade infections that go undetected by standard labs. In-depth testing and targeted antimicrobials (conventional or herbal) are often needed.
Full page on bacterial infections coming soon.
Fungal Infections
Fungal overgrowth, especially Candida, can contribute to gut dysbiosis, brain fog, mood swings, and skin issues. Mold exposure and antibiotics often tip the balance in favor of yeast, especially in kids with weakened detox pathways. Fungal byproducts (mycotoxins) can further dysregulate the immune system and inflame the brain. For some kids, clearing yeast and supporting the microbiome becomes a major turning point.
A full section on fungal overgrowth and antifungal strategies is on the way.
Parasites
Parasites are often overlooked, but they can be a significant hidden burden, especially in kids with chronic symptoms that don’t fully resolve. Parasites produce toxins, disrupt digestion, and dysregulate the immune system. Kids with a history of travel, exposure to animals, or persistent gut issues may benefit from deeper evaluation and gentle, strategic parasite cleansing protocols.
Content coming soon: how to recognize, test for, and treat parasites safely.
Biofilms | The Microbe’s Shield
Biofilms are mucous-like substances that act as a shield, hiding the microbes from the immune system. Safely behind the biofilm, these microbes can lie dormant for years, evading detection and eradication. They may resurface and trigger illness when the body is under significant stress, such as during serious illness or times of emotional strain.
When they do, they release enzymes that break down connective tissue around our barriers, making it easier for more pathogens to enter the bloodstream. This tissue damage often causes symptoms common to autoimmune diseases: brain fog, joint pain, fatigue, headaches, anxiety, and other systemic issues.
Identifying Biofilm as an issue and ways to tackle it. Coming Soon.
